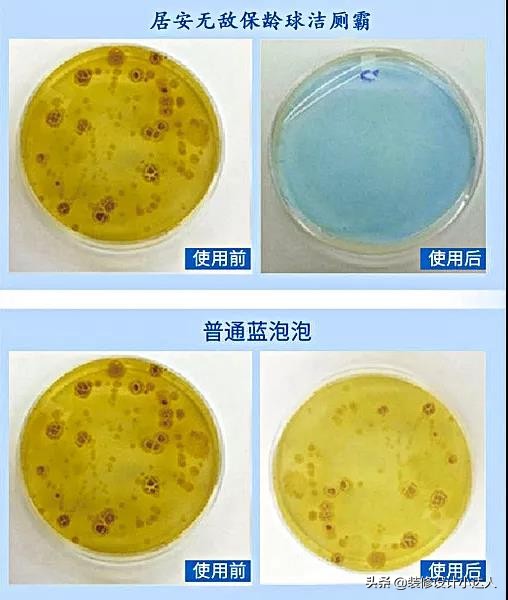
十件让家里变宽敞的居家好物,家里必备的家居好物

宅在家的第50天,除了追剧打游戏,给我最深刻的体会就是拥有一个舒适高效的家是多么重要。这些往往体现在细节之处,我们全家宅的日子里,多亏了这10件家居好物,让我们越宅越舒服!

1、空气纤维坐垫
居家办公的日子也不舒服,毕竟全天视频会议直播工作,一天下来依然腰酸背痛。多亏了朋友送的空气纤维坐垫,这些天明显感觉腰椎不酸了,轻松多了~

空气纤维坐垫采用日本进口高分*弹子**性科技材料,在200℃与13℃的温差下在水中按照水波纹一体成型,不用一滴胶,安全环保。

坐上去非常透气舒服,感觉整个人坐在“空气”上,六面透气,夏天不热,摆脱坐湿裙子的尴尬,冬天也不闷。

而且回弹性更好,多点位支撑,减轻腰椎压力,让血液循环更畅通,有种整个人放松的感觉~实际体验极佳!

空气纤维坐垫两面设计了不同密度,一面偏硬,一面偏软,适合各种椅子,以及各种人群,比如上班族、学生*党**、司机等等。

宅在家这段时间,我随时随地都带着空气纤维坐垫,办公时放在椅子上,追剧放在沙发上,甚至放在地板上,主要是它真的太舒服啦~

每天坐在弹软的空气坐垫上,享受被包裹的感觉,真的很幸福~

还有一点就是清洗方便,只要把坐垫放在水龙头下面冲洗就可以了。
菠萝斑马空气纤维粉丝坐垫一个装两个装
¥99
购买
2、OOU多功能菜板
在这个超长假期中,几乎每个人都成了料理达人,在家里烹饪各种美食。如果没有一个好用的菜板,即使像烹饪出美味佳肴,仍然无能为力。

我家之前都选竹菜板,但用上半年就开裂,而且刀痕处也易藏污纳垢。年前入手了一个OOU多功能菜板,采用日本进口抗菌黑科技Ag+防护,不会开裂、更不会发霉,长效抑菌。

OOU多功能菜板比普通菜板更容易清洗,只需轻轻一擦,一点残留都没有,也可以用水直接冲洗。

OOU多功能菜板不仅正面能用,背面也可以,凹槽设计可以用来做杯垫、轻松沥水,或是当果盘,摆在桌子上,美观又大方。

此外,菜板自带磨刀器,无论大刀、小刀刷刷两下,又快又亮,刀具更不易生锈,延长刀具使用寿命。

之所以说这款菜板多功能,因为还具备打泥功能,轻松磨出蒜泥、苹果泥、萝卜泥...

这款菜板真是功能强大,防霉抗菌又安全。有了它,这个假期,我进入厨房的次数都多了。
OOU多功能防霉菜板
¥99
购买
3、魔力豆豆擦
吃饭是除了睡觉最让人感到幸福的事情了,但吃饭一时爽,饭后洗碗让多少幸福家庭吵得面红耳赤?油腻腻的餐具,再加上脏兮兮、沾满菜叶的清洁棉,看着就恶心...

针对这个头疼问题,今天给大家安利一个专为厨房清洁而生的魔力豆豆擦,轻松解决油污难题,让家庭更幸福~

魔力豆豆擦比普通清洁棉更好用,1个顶10个,而且是双面的,上层魔力豆,柔软吸水更洁净,下层原生木浆棉,清洁顽固油渍。

魔力豆豆擦能不用水不用洗洁精,就能把餐具擦干净。

厨房里油渍最多的油烟机、灶台以及洗完碗筷狼藉不堪的洗手池,用魔力豆豆擦,轻轻一抹,也能变得异常干净,省了不少力气和时间。

沾满油渍的魔力豆豆擦,只要打开水龙头冲一冲,就变干净了,比普通清洁棉方便太多了。

因为这款清洁擦含有500个清洁魔力豆,在清洁力达到的同时,更不会划伤锅底。

此外,魔力豆豆擦自带蜂窝气孔,能够快速干燥,不易滋生细菌,用起来更卫生~

赶快扔掉家里的清洁棉吧,试试这款魔力豆豆擦,给你不一样的体验哦~
moyori魔力清洁豆豆擦
¥39
购买
4、管道疏通剂
洗碗的问题解决了,厨房还有一个令人头疼的事情,就是洗菜池堵塞,不可能下手清理吧。

这时候如果家里有管道疏通剂,几分钟的时间轻松解决。无论是菜叶、肉片,还是调料统统败在管道疏通剂手下,最终被溶解成液体,顺着水流排出。

即使是卫生间下水道被头发堵塞,只要倒入管道疏通剂,发丝就会被溶解,变成黑乎乎的液体。

一瓶管道疏通剂,轻松解决家里厨房洗菜池堵塞,甚至马桶堵塞也能搞定。
管道疏通剂厨房油污厕所马桶强力通下水道神器卫生间管道
¥22.8
购买
5、魔术裤架
衣柜里的裤子比较多,都是叠放在一起,每次找一条想穿的裤子,都要全部抽出来看一遍,结果才整理的衣柜又乱了...

为了解决这样的困扰,我给大家推荐一款魔术裤架,把裤子悬挂起来,拿取方便,更不易出现褶皱。

每个小杆都能沿着轨道抽拉出来,想穿哪条就抽哪根杆子,非常方便。

外出旅行,也可以带着,只要把裤子围绕裤架卷起来,放在行李箱,不占空间。

家里裤子多的小伙伴,可以入手哦~
衣柜裤子收纳架 多功能魔术裤架 不锈钢衣架 伸缩裤架
¥27
购买
6、保龄球洁厕霸
很多时候,马桶用了一周的时间,就比较脏了,内壁上残留很多细菌,还会散发异味。每次上完厕所立即清洁马桶根本不现实。
所以,不少家庭会在马桶水箱里放蓝泡泡,但蓝泡泡使用周期短,有时候还会挂壁,依然要人为清洁。

而这款保龄球洁厕霸,采用浓缩凝胶配方,搭配科学缓释技术,能够在放入水箱后发挥强效的清洁作用。无论多脏的污垢和尿碱,都能轻松被冲走,免去刷马桶的麻烦。

丢进去一瓶,半年都不用管,持续保持良好的清洁效果,还有自然花果芬芳,洁净又安全。

保龄球洁厕霸主要成分是柠檬酸以及各种有机酸,能把马桶的边边角角清理的非常干净,还能消灭马桶内隐藏的细菌,呵护家人健康。
1瓶可以使用1200次,180天,和普通的蓝泡泡相比,一瓶抵过80粒,超级省。

马桶洁净如新,每天都会有好心情,赶快试试~
居安保龄球洁厕霸
¥49
购买
7、洗衣机除霉剂
洗衣机方便了大家的生活,但洗衣机都有一个弊端,就是时间久了,洗衣机槽里有霉斑生成,尤其是滚筒洗衣机,它的胶圈最容易发霉,又不易清除,衣物也容易染上细菌。

现在有专除顽固霉菌的除霉剂,渗入霉菌深层,分解底层霉斑,快速除霉,并抑制霉斑再次产生。

除了洗衣机皮圈,洗手盆周边、瓷砖缝隙、冰箱密封条、马桶粘胶处,都能用它除霉。

每一处有霉菌的地方都能用到它,让家更洁净。
迈点除霉剂滚筒洗衣机胶圈去霉菌瓷砖冰箱胶条卫生间厨房家用
¥21.9
购买
8、硅藻泥脚垫
卫生间防滑无论是装修,还是入住后期都比较重点考虑的事情,最好在卫生间门口放个防滑脚垫。
传统的脚垫一般采用橡胶材质,防滑性差,不吸水,时间久了,容易藏污纳垢。

不如使用吸水快、速干的硅藻泥脚垫,湿漉漉的双脚一踩上去,双脚瞬间就干透了。

硅藻泥脚垫有硅藻土做成,天然无害,其表面有无数小孔,有效吸附甲醛、苯等有害物质,在保持卫生间干爽的同时,还能起到净化空气的作用。

硅藻泥脚垫清洁和保养起来也特别方便,用水冲洗或擦拭一下,就可恢复原貌。

如果卫生间放一块逼格满满的硅藻泥脚垫,简直就是完美~
【爆款】天然硅藻泥脚垫浴室防滑垫硅藻土吸水速干神器
¥29
购买
9、蒸汽拖把
每次打扫卫生都非常累人,尤其是黏乎乎的厨房、满地鞋印的地板、或是沾了茶渍的地毯,让人抓狂。但家里的拖把怎么拖都拖不干净,还费力气。

直到遇见刚刚入手的美克斯蒸汽拖把,能一机多用,杀菌去油,所到之处干干净净。

美克斯蒸汽拖把有着1300w大功率加热,快速释放100℃的高温蒸汽,清洁不用等待。不管哪里,超快速解决问题。

有了它,厨房撒了汤汁、或是油腻腻的污渍,轻轻一拖即净。

就连最难清理的瓷砖缝隙也能清洁的非常干净,休想藏污纳垢。

拖把的推杆可以前后旋转70°,非常灵活,清洁床下灰尘只需按压推杆就可以,再也不用弯腰跪地了。

此外,还可以拿下推杆,该手持使用。换上小圆刷,用来清洁灶炉,边刷边清洁~

还可以清洁布艺沙发或是地毯,喷一喷,除菌除螨,消除藏在深处的污垢,

除了以上这些,马桶也可以用美克斯蒸汽拖把喷一喷,有效消灭细菌,更加健康卫生。

有了它,能轻松打扫家里每一个角落,顺便还给家里做了除螨、消毒,尤其在这段时间里,家里消毒全靠它,真的太好用了~
MKS美克斯蒸汽拖把
¥568
购买
10、香薰机
现在的年轻人比较重视生活的品味,在工作或闲暇之余,尽享属于自己的美好时光。房间氛围除了灯光和音乐,空气中弥漫着淡淡的香气,也能提升生活品质。那么,香薰机自然少不了~

香薰机产生大量活氧负离子,与空气中的有害气体分子产生反应,并综合清除,让空气变好,还会带着香味。

把香薰机放在办公室或书房,它散发出来的淡淡芳香可提神醒脑。即使忙碌一整天,透过香薰机带来的阵阵幽香,也能让人倍感放松、舒心。

香薰机开启后没有任何噪音,喷出的水雾超级细腻,呵护你的肌肤;还可用来当作小夜灯,在每一个寒冷的冬夜温暖照亮你的心~
家用迷你600ml香薰机加湿器大容量空气雾化器
¥89
购买
在这个超长假期里,这些就是让我过得很舒适的好“宝贝”,你家有没有让你越宅越舒服的家居好物呢?可以在评论区和大家分享哦~